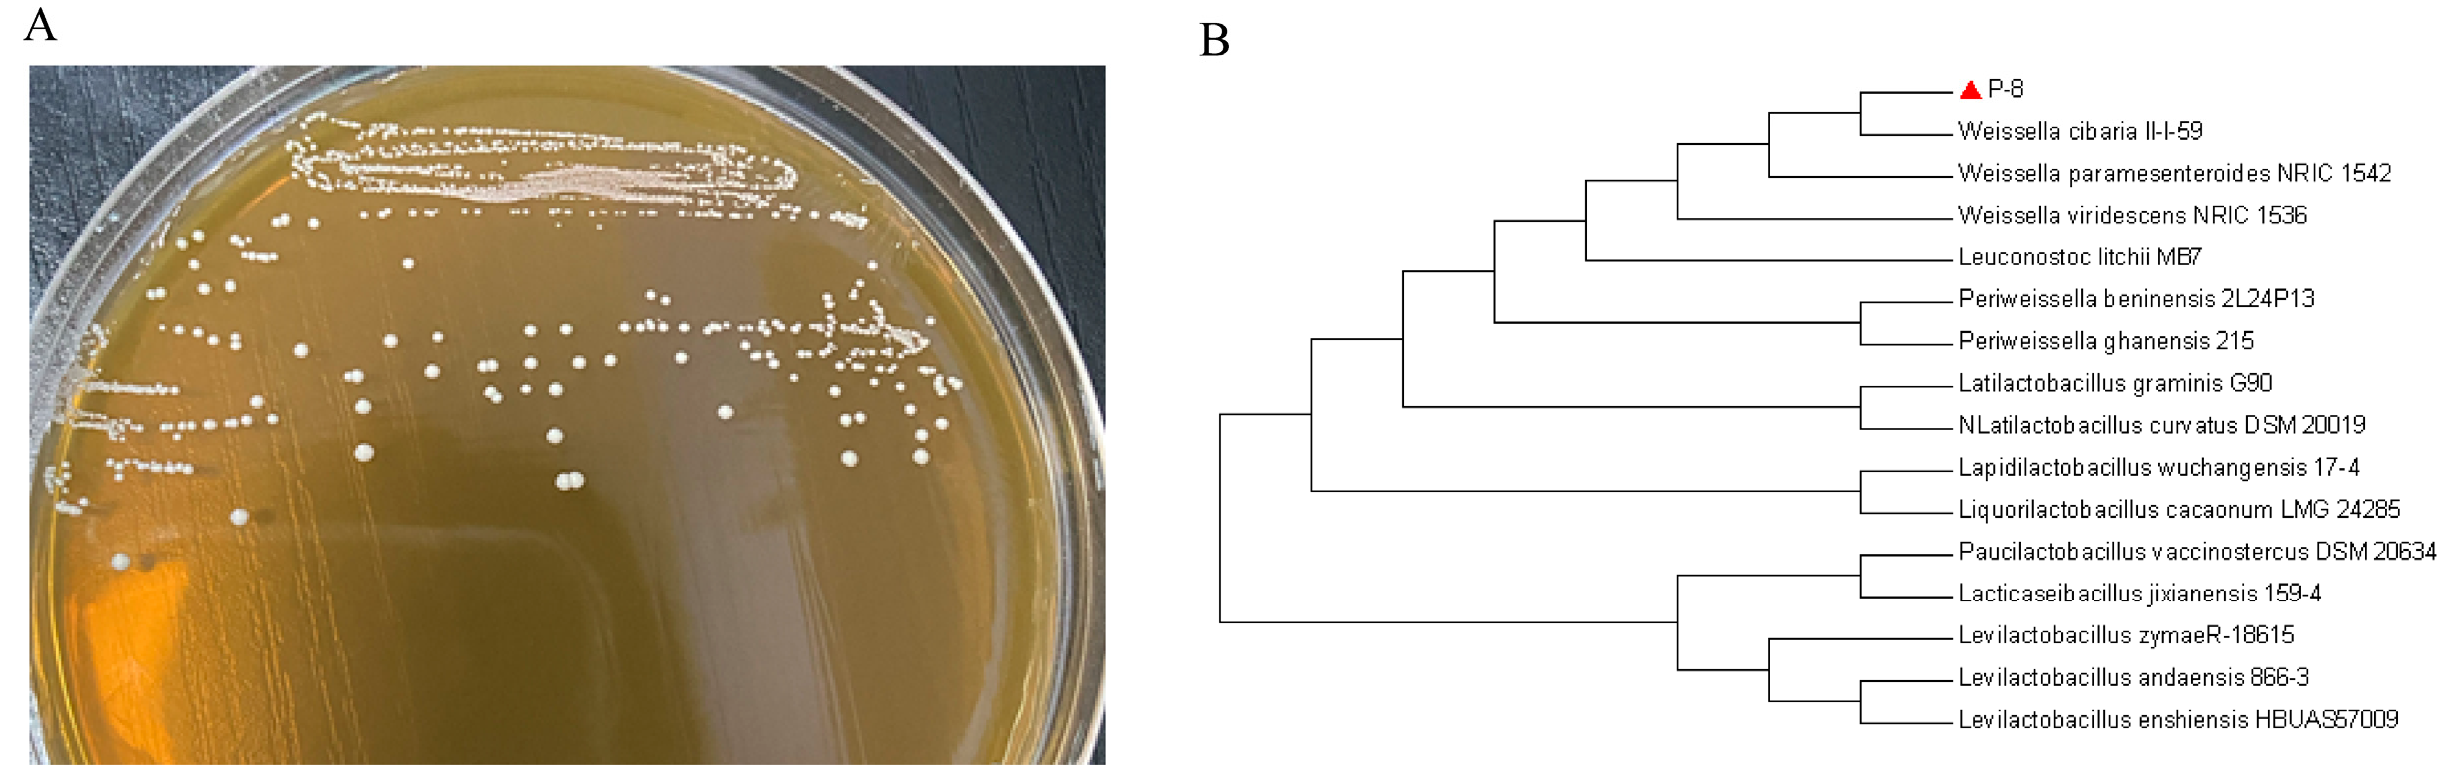
Foods 13 01133 g002

Weissella cibaria Relieves Gut Inflammation Caused by Escherichia coli through Inflammation Modulation and Gut Microbiota Regulation
Abstract
1. Introduction
2. Materials and Methods
2.1. Bacterial Strain Identification
2.2. Sequencing and Phylogenetic Analysis
2.3. Characteristic Analysis of Weissella Cibaria P-8
2.3.1. Growth Kinetic Curve, Antibacterial Activity, and Drug Sensitivity Test
2.3.2. Thermal and Enzymatic Stability
2.3.3. Tolerance to Low pH
2.3.4. Tolerance to 0.3% Bile Salt
2.3.5. Adhesion of W. cibaria P-8 to Hydrocarbons
2.3.6. Autoagglutination Assay
2.4. Oral W. cibaria P-8 Administration and Sample Collection in Mouse Study
2.5. Biochemical Assays of Serum
2.6. Hematoxylin and Eosin Staining of Liver and Gut
2.7. Fecal Microbiota Analysis by 16S rRNA Gene Sequencing
2.8. Statistical Analysis
3. Results
3.1. Strain Identification
3.2. Characteristics of W. cibaria P-8
3.3. Effects of W. cibaria P-8 in the Inflammation of Serum and Gut in Mice
3.4. Alleviation of Liver and Gut Morphologies in Mice Fed with W. cibaria P-8 and Challenged with E. coli B2
3.5. Colonization of W. cibaria P-8 in the Gut and the Composition of Gut Microbiota in Mice
4. Discussion
5. Conclusions
Supplementary Materials
Author Contributions
Funding
Institutional Review Board Statement
Informed Consent Statement
Data Availability Statement
Conflicts of Interest
References
- Dougherty, M.W.; Jobin, C. Intestinal bacteria and colorectal cancer: Etiology and treatment. Gut Microbes 2023, 15, 2185028. [Google Scholar] [CrossRef] [PubMed]
- Guinane, C.M.; Cotter, P.D. Role of the gut microbiota in health and chronic gastrointestinal disease: Understanding a hidden metabolic organ. Ther. Adv. Gastroenterol. 2013, 6, 295–308. [Google Scholar] [CrossRef] [PubMed]
- Schwartz, K.L.; Morris, S.K. Travel and the spread of drug-resistant bacteria. Curr. Infect. Dis. Rep. 2018, 20, 29. [Google Scholar] [CrossRef] [PubMed]
- Pessione, E. Lactic acid bacteria contribution to gut microbiota complexity: Lights and shadows. Front. Cell. Infect. Microbiol. 2012, 2, 86. [Google Scholar] [CrossRef] [PubMed]
- Thomas, C.M.; Versalovic, J. Probiotics-host communication: Modulation of signaling pathways in the intestine. Gut Microbes 2010, 1, 148. [Google Scholar] [CrossRef]
- Ahmed, S.; Singh, S.; Singh, V.; Roberts, K.D.; Zaidi, A.; Rodriguez-Palacios, A. The Weissella genus: Clinically treatable bacteria with antimicrobial/probiotic effects on inflammation and cancer. Microorganisms 2022, 10, 2427. [Google Scholar] [CrossRef]
- Sujaya, I.N.; Dharmika, I.A.G.W.; Suwardana, G.N.R.; Mariadi, I.K.; Arijana, I.G.K.N.; Winaya, I.B.O.; Nocianitri, K.A.; Ramona, Y.; Fatmawati, N.N.D. Weissella confusa f213 ameliorated inflammation and maintained intestinal mucosa integrity in chemically induced colitis rats. BMC Res. Notes 2023, 16, 178. [Google Scholar] [CrossRef]
- El-Mekkawy, R.M.; Hamour, N.E.; Hassanein, W.A.; Allam, A.A. Evaluation of the antibacterial activity of Weissella confusa k3 cell-free supernatant against extended-spectrum βeta lactamase (ESBL) producing uropathogenic Escherichia coli U60. Saudi J. Biol. Sci. 2023, 30, 103595. [Google Scholar] [CrossRef]
- Bao, R.; Liu, S.; Ji, C.; Liang, H.; Yang, S.; Yan, X.; Zhou, Y.; Lin, X.; Zhu, B. Shortening Fermentation Period and Quality Improvement of Fermented Fish, Chouguiyu, by Co-inoculation of Lactococcus lactis M10 and Weissella cibaria M3. Front. Microbiol. 2018, 9, 3003. [Google Scholar] [CrossRef]
- Tang, Q.; Xu, E.; Wang, Z.; Xiao, M.; Cao, S.; Hu, S.; Wu, Q.; Xiong, Y.; Jiang, Z.; Wang, F.; et al. Dietary Hermetia illucens larvae meal improves growth performance and intestinal barrier function of weaned pigs under the environment of enterotoxigenic Escherichia coli k88. Front. Nutr. 2022, 8, 812011. [Google Scholar] [CrossRef]
- Zhong, Y.; Fu, D.; Deng, Z.; Tang, W.; Mao, J.; Zhu, T.; Zhang, Y.; Liu, J.; Wang, H. Lactic acid bacteria mixture isolated from wild pig alleviated the gut inflammation of mice challenged by Escherichia coli. Front. Immunol. 2022, 13, 822754. [Google Scholar] [CrossRef] [PubMed]
- Amat, S.; Holman, D.B.; Timsit, E.; Schwinghamer, T.; Alexander, T.W. Evaluation of the nasopharyngeal microbiota in beef cattle transported to a feedlot, with a focus on lactic acid-producing bacteria. Front. Microbiol. 2019, 10, 1988. [Google Scholar] [CrossRef] [PubMed]
- Lin, T.; Chen, C.; Chen, B.; Shaw, J.; Chen, Y. Optimal economic productivity of exopolysaccharides from lactic acid bacteria with production possibility curves. Food Sci. Nutr. 2019, 7, 2336–2344. [Google Scholar] [CrossRef] [PubMed]
- Rocha-Mendoza, D.; Kosmerl, E.; Miyagusuku-Cruzado, G.; Giusti, M.M.; Jiménez-Flores, R.; García-Cano, I. Growth of lactic acid bacteria in milk phospholipids enhances their adhesion to caco-2 cells. J. Dairy Sci. 2020, 103, 7707–7718. [Google Scholar] [CrossRef] [PubMed]
- Khan, I.; Zhang, H.; Liu, W.; Zhang, L.; Peng, F.; Chen, Y.; Zhang, Q.; Zhang, G.; Zhang, W.; Zhang, C. Identification and bioactivity evaluation of secondary metabolites from Antarctic-derived Penicillium chrysogenum CCTCC M 2020019. RSC Adv. 2020, 10, 20738–20744. [Google Scholar] [CrossRef] [PubMed]
- Qin, Y.; Li, J.; Wang, Q.; Gao, K.; Zhu, B.; Lv, N. [Identification of lactic acid bacteria in commercial yogurt and their antibiotic resistance]. J. Wei Sheng Wu Xue Bao 2013, 53, 889–897. [Google Scholar] [CrossRef]
- Manganelli, M.; Malfatti, F.; Samo, T.J.; Mitchell, B.G.; Wang, H.; Azam, F. Major role of microbes in carbon fluxes during austral winter in the southern drake passage. PLoS ONE 2009, 4, e6941. [Google Scholar] [CrossRef] [PubMed]
- Abdelsamad, N.O.; Esawy, M.A.; Mahmoud, Z.E.; El-Shazly, A.I.; Elsayed, T.R.; Gamal, A.A. Evaluation of different bacterial honey isolates as probiotics and their efficient roles in cholesterol reduction. World J. Microbiol. Biotechnol. 2022, 38, 106. [Google Scholar] [CrossRef]
- Bamgbose, T.; Alberdi, P.; Abdullahi, I.O.; Inabo, H.I.; Bello, M.; Sinha, S.; Anvikar, A.R.; Mateos-Hernandez, L.; Torres-Maravilla, E.; Bermúdez-Humarán, L.G.; et al. Functional characterization of α-gal producing lactic acid bacteria with potential probiotic properties. Sci. Rep. 2022, 12, 7484. [Google Scholar] [CrossRef]
- Zaghloul, E.H.; Ibrahim, M.I.A. Production and characterization of exopolysaccharide from newly isolated marine probiotic lactiplantibacillus plantarum ei6 with in vitro wound healing activity. Front. Microbiol. 2022, 13, 903363. [Google Scholar] [CrossRef]
- Pan, Y.; Ning, Y.; Hu, J.; Wang, Z.; Chen, X.; Zhao, X. The preventive effect of Lactobacillus plantarum ZS62 on DSS-induced IBD by regulating oxidative stress and the immune response. Oxidative Med. Cell. Longev. 2021, 2021, 9416794. [Google Scholar] [CrossRef] [PubMed]
- Filgueira, D.; Bolaño, C.; Gouveia, S.; Moldes, D. Enzymatic functionalization of wood as an antifouling strategy against the marine bacterium Cobetia marina. Polymers 2021, 13, 3795. [Google Scholar] [CrossRef] [PubMed]
- Nagpal, R.; Wang, S.; Ahmadi, S.; Hayes, J.; Gagliano, J.; Subashchandrabose, S.; Kitzman, D.W.; Becton, T.; Read, R.; Yadav, H. Human-origin probiotic cocktail increases short-chain fatty acid production via modulation of mice and human gut microbiome. Sci. Rep. 2018, 8, 12649. [Google Scholar] [CrossRef] [PubMed]
- Grujović, M.; Mladenović, K.G.; Nikodijević, D.D.; Čomić, L.R. Autochthonous lactic acid bacteria—Presentation of potential probiotics application. Biotechnol. Lett. 2019, 41, 1319–1331. [Google Scholar] [CrossRef] [PubMed]
- Liu, X.; Wu, C.; Han, D.; Liu, J.; Liu, H.; Jiang, Z. Partially hydrolyzed guar gum attenuates d-galactose-induced oxidative stress and restores gut microbiota in rats. Int. J. Mol. Sci. 2019, 20, 4861. [Google Scholar] [CrossRef] [PubMed]
- van Zoggel, H.; Carpentier, G.; Dos Santos, C.; Hamma-Kourbali, Y.; Courty, J.; Amiche, M.; Delbé, J. Antitumor and angiostatic activities of the antimicrobial peptide dermaseptin B2. PLoS ONE 2012, 7, e44351. [Google Scholar] [CrossRef] [PubMed]
- Xu, X.; Wu, J.; Jin, Y.; Huang, K.; Zhang, Y.; Liang, Z. Both Saccharomyces boulardii and Its Postbiotics Alleviate Dextran Sulfate Sodium-Induced Colitis in Mice, Association with Modulating Inflammation and Intestinal Microbiota. Nutrients 2023, 15, 1484. [Google Scholar] [CrossRef] [PubMed]
- Wang, X.; Ji, Y.; Jin, D.; Qi, J.; Hou, X.; Zhao, W.; Zhou, S.; Zhang, C.; Luo, Y.; An, P.; et al. Natural Polysaccharide β-Glucan Protects against Doxorubicin-Induced Cardiotoxicity by Suppressing Oxidative Stress. Nutrients 2022, 14, 906. [Google Scholar] [CrossRef]
- Shi, M.; Song, R.; Gu, L. Different Regulatory Effects of Heated Products and Maillard Reaction Products of Half-Fin Anchovy Hydrolysates on Intestinal Antioxidant Defense in Healthy Animals. Int. J. Mol. Sci. 2023, 24, 2355. [Google Scholar] [CrossRef]
- Yu, Z.; Cao, M.; Peng, J.; Wu, D.; Li, S.; Wu, C.; Qing, L.; Zhang, A.; Wang, W.; Huang, M.; et al. Lacticaseibacillus casei T1 attenuates Helicobacter pylori-induced inflammation and gut microbiota disorders in mice. BMC Microbiol. 2023, 23, 39. [Google Scholar] [CrossRef]
- Wang, R.; Jiang, L.; Zhang, M.; Zhao, L.; Hao, Y.; Guo, H.; Sang, Y.; Zhang, H.; Ren, F. The Adhesion of Lactobacillus salivarius REN to a Human Intestinal Epithelial Cell Line Requires S-layer Proteins. Sci. Rep. 2017, 7, srep44029. [Google Scholar] [CrossRef]
- Zhang, J.; Wan, S.; Gui, Q. Comparison of safety, effectiveness and serum inflammatory factor indexes of Saccharomyces boulardii versus Bifidobacterium triple viable in treating children with chronic diarrhea: A randomized trial. Transl. Pediatr. 2021, 10, 1677–1685. [Google Scholar] [CrossRef] [PubMed]
- Zeng, H.; Liu, Y.; Huang, K.; Chen, H.; Yang, B.; Wang, J. Lactiplantibacillus plantarum A1, C1 and C10 Are Potential Probiotics Isolated from Pineapple Residual Silage. Microorganisms 2023, 11, 29. [Google Scholar] [CrossRef] [PubMed]
- Chen, T.; Wang, L.; Li, Q.; Long, Y.; Lin, Y.; Yin, J.; Zeng, Y.; Huang, L.; Yao, T.; Abbasi, M.N.; et al. Functional probiotics of lactic acid bacteria from Hu sheep milk. BMC Microbiol. 2020, 20, 228. [Google Scholar] [CrossRef]
- Sato, S.T.A.; Marques, J.M.; Freitas, A.d.L.d.; Progênio, R.C.S.; Nunes, M.R.T.; Massafra, J.M.d.V.; Moura, F.G.; Rogez, H. Isolation and Genetic Identification of Endophytic Lactic Acid Bacteria From the Amazonian Açai Fruits: Probiotics Features of Selected Strains and Their Potential to Inhibit Pathogens. Front. Microbiol. 2021, 11, 610524. [Google Scholar] [CrossRef]
- Yudkin, J.S.; Yajnik, C.S.; Mohamed-Ali, V.; Bulmer, K. High levels of circulating proinflammatory cytokines and leptin in urban, but not rural, Indians. A potential explanation for increased risk of diabetes and coronary heart disease. Diabetes Care 1999, 22, 363–364. [Google Scholar] [CrossRef]
- Paladino, L.; Rappa, F.; Barone, R.; Macaluso, F.; Zummo, F.P.; David, S.; Szychlinska, M.A.; Bucchieri, F.; de Macario, E.C.; Macario, A.J.L.; et al. NF-kB Regulation and the Chaperone System Mediate Restorative Effects of the Probiotic Lactobacillus fermentum LF31 in the Small Intestine and Cerebellum of Mice with Ethanol-Induced Damage. Biology 2023, 12, 1394. [Google Scholar] [CrossRef] [PubMed]
- Li, J.; Li, Z.; Dong, P.; Liu, P.; Xu, Y.; Fan, Z. Effects of parasternal intercostal block on surgical site wound infection and pain in patients undergoing cardiac surgery: A meta-analysis. Int. Wound J. 2023, 21, e14433. [Google Scholar] [CrossRef] [PubMed]
- Cao, J.; Liu, Q.; Hao, H.; Bu, Y.; Tian, X.; Wang, T.; Yi, H. Lactobacillus paracasei X11 Ameliorates Hyperuricemia and Modulates Gut Microbiota in Mice. Front. Immunol. 2022, 13, 940228. [Google Scholar] [CrossRef]
- Li, N.; Pang, B.; Liu, G.; Zhao, X.; Xu, X.; Jiang, C.; Yang, B.; Liu, Y.; Shi, J. Lactobacillus rhamnosus from human breast milk shows therapeutic function against foodborne infection by multi-drug resistant Escherichia coli in mice. Food Funct. 2020, 11, 435–447. [Google Scholar] [CrossRef]
- Fu, Q.; Qiu, R.; Chen, L.; Chen, Y.; Qi, W.; Cheng, Y. Music prevents stress-induced depression and anxiety-like behavior in mice. Transl. Psychiatry 2023, 13, 317. [Google Scholar] [CrossRef]
- Zhang, Y.; Li, S.; Liu, H.; Long, W.; Zhang, X.-D. Enzyme-Like Properties of Gold Clusters for Biomedical Application. Front. Chem. 2020, 8, 219. [Google Scholar] [CrossRef]
- Park, H.-E.; Kang, K.-W.; Kim, B.-S.; Lee, S.-M.; Lee, W.-K. Immunomodulatory Potential of Weissella cibaria in Aged C57BL/6J Mice. J. Microbiol. Biotechnol. 2017, 27, 2094–2103. [Google Scholar] [CrossRef]
- Lu, H.; Zhang, L.; Xiao, J.; Wu, C.; Zhang, H.; Chen, Y.; Hu, Z.; Lin, W.; Xie, Q.; Li, H. Effect of feeding Chinese herb medicine ageratum-liquid on intestinal bacterial translocations induced by H9N2 AIV in mice. Virol. J. 2019, 16, 24. [Google Scholar] [CrossRef] [PubMed]
- Koirala, R.; Gargari, G.; Arioli, S.; Taverniti, V.; Fiore, W.; Grossi, E.; Anelli, G.M.; Cetin, I.; Guglielmetti, S. Effect of oral consumption of capsules containing Lactobacillus paracasei LPC-S01 on the vaginal microbiota of healthy adult women: A randomized, placebo-controlled, double-blind crossover study. FEMS Microbiol. Ecol. 2020, 96, fiaa084. [Google Scholar] [CrossRef]
- Bouyahya, A.; El Omari, N.; EL Hachlafi, N.; El Jemly, M.; Hakkour, M.; Balahbib, A.; El Menyiy, N.; Bakrim, S.; Mrabti, H.N.; Khouchlaa, A.; et al. Chemical Compounds of Berry-Derived Polyphenols and Their Effects on Gut Microbiota, Inflammation, and Cancer. Molecules 2022, 27, 3286. [Google Scholar] [CrossRef]
- Lv, J.; Qi, P.; Bai, L.-H.; Yan, X.-D.; Zhang, L. Review of the relationship and underlying mechanisms between the Qinghai–Tibet plateau and host intestinal flora. Front. Microbiol. 2022, 13, 1055632. [Google Scholar] [CrossRef] [PubMed]
- Lim, S.K.; Kwon, M.-S.; Lee, J.; Oh, Y.J.; Jang, J.-Y.; Lee, J.-H.; Park, H.W.; Nam, Y.-D.; Seo, M.-J.; Roh, S.W.; et al. Weissella cibaria WIKIM28 ameliorates atopic dermatitis-like skin lesions by inducing tolerogenic dendritic cells and regulatory T cells in BALB/c mice. Sci. Rep. 2017, 7, 40040. [Google Scholar] [CrossRef]
- Xue, F.; Shi, L.; Li, Y.; Ni, A.; Ma, H.; Sun, Y.; Chen, J. Effects of replacing dietary Aureomycin with a combination of plant essential oils on production performance and gastrointestinal health of broilers. Poult. Sci. 2020, 99, 4521–4529. [Google Scholar] [CrossRef]
- Wang, W.; Zhu, T.; Wan, P.; Wei, Q.; He, J.; Lai, F.; Fu, Q. SPARC plays an important role in the oviposition and nymphal development in Nilaparvata lugens Stål. BMC Genom. 2022, 23, 682. [Google Scholar] [CrossRef]
- Cao, Y.; Zhang, S.; Tang, L.; Chen, Y.; Jiang, S.; Liu, L.; Gao, X. Exploring the effects of Qijiao Shengbai capsule on leukopenic mice from the perspective of intestinbased on metabolomics and 16S rRNA sequencing. Heliyon 2023, 9, e19949. [Google Scholar] [CrossRef] [PubMed]

| Gram Reaction and Strains | Source | Is It Pathogenic | Inhibitory Circle Diameter (mm) |
|---|---|---|---|
| Gram-negative bacteria | |||
| Escherichia coli B2 | Type strain | Yes | 24.67 ± 0.58 |
| Pseudomonas aeruginosa Z1 | Lung of cattle | Yes | 21.33 ± 0.58 |
| Salmonella H9812 | Intestine of cattle | Yes | 20.33 ± 0.58 |
| Shigella castellani Z1 | Intestine of cattle | Yes | 7.33 ± 0.58 |
| Acinetobacter baumannii C1 | Intestine of chicken | Yes | 15.33 ± 0.58 |
| Gram-positive bacteria | |||
| Staphylococcus aureus ATCC25923 | Standard strain | Yes | 15.33 ± 0.58 |
| Methicillin-resistant Staphylococcus | Feces of cattle | Yes | 12.67 ± 0.58 |
| aureus (MRSA) |
Disclaimer/Publisher’s Note: The statements, opinions and data contained in all publications are solely those of the individual author(s) and contributor(s) and not of MDPI and/or the editor(s). MDPI and/or the editor(s) disclaim responsibility for any injury to people or property resulting from any ideas, methods, instructions or products referred to in the content. |
© 2024 by the authors. Licensee MDPI, Basel, Switzerland. This article is an open access article distributed under the terms and conditions of the Creative Commons Attribution (CC BY) license (https://creativecommons.org/licenses/by/4.0/).
Share and Cite
Liu, X.; Jiang, N.; Wang, X.; Yan, H.; Guan, L.; Kong, L.; Chen, J.; Zhang, H.; Ma, H. Weissella cibaria Relieves Gut Inflammation Caused by Escherichia coli through Inflammation Modulation and Gut Microbiota Regulation. Foods 2024, 13, 1133. https://doi.org/10.3390/foods13071133
Liu X, Jiang N, Wang X, Yan H, Guan L, Kong L, Chen J, Zhang H, Ma H. Weissella cibaria Relieves Gut Inflammation Caused by Escherichia coli through Inflammation Modulation and Gut Microbiota Regulation. Foods. 2024; 13(7):1133. https://doi.org/10.3390/foods13071133
Chicago/Turabian StyleLiu, Xiaoyu, Nan Jiang, Xinyue Wang, Haowen Yan, Lili Guan, Lingcong Kong, Jingrui Chen, Haipeng Zhang, and Hongxia Ma. 2024. "Weissella cibaria Relieves Gut Inflammation Caused by Escherichia coli through Inflammation Modulation and Gut Microbiota Regulation" Foods 13, no. 7: 1133. https://doi.org/10.3390/foods13071133
APA StyleLiu, X., Jiang, N., Wang, X., Yan, H., Guan, L., Kong, L., Chen, J., Zhang, H., & Ma, H. (2024). Weissella cibaria Relieves Gut Inflammation Caused by Escherichia coli through Inflammation Modulation and Gut Microbiota Regulation. Foods, 13(7), 1133. https://doi.org/10.3390/foods13071133






